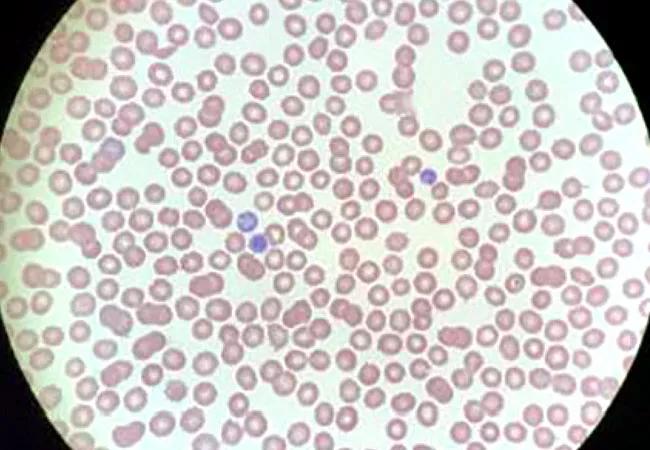

When SARS-CoV-2 leads to severe secondary immune thrombocytopenia
Image content: This image is available to view online.
View image online (https://assets.clevelandclinic.org/transform/d42c3be1-3ef3-4276-bb36-7ddb15a9a105/21-CCC-2144209-SevereAsymptomatic-COVID-CCJM-CQD_650x450_jpg)
21-CCC-2144209-SevereAsymptomatic-COVID-CCJM-CQD_650x450
By Lauren M. Granat, DO, MS; Achintya D. Singh, MBBS, MD; Matthew Cortese, MD, MPH; Vicente Velez, MD, FACP, FHM; and Alan Lichtin, MD
Advertisement
Cleveland Clinic is a non-profit academic medical center. Advertising on our site helps support our mission. We do not endorse non-Cleveland Clinic products or services. Policy
A 35-year-old woman with a medical history significant only for recently diagnosed essential hypertension presented to an urgent-care facility with easy bruising, petechiae, and gingival bleeding. She said that she had noticed large ecchymoses from minimal trauma on her upper and lower extremities for the past week, as well as a petechial rash. A complete blood cell count at that time revealed a platelet count of 3.0 × 109/L (reference range 150–400 × 109/L), and she was told to go to the nearest emergency department.
In the emergency department, repeat testing confirmed that her platelet count was indeed only 3.0 × 109/L, while the rest of her complete blood cell count values were unremarkable (Table 1). Her blood pressure was 167/104 mm Hg, heart rate 80 beats per minute, respiratory rate 16 breaths per minute, and oxygen saturation 99% on room air.

Image content: This image is available to view online.
View image online (https://assets.clevelandclinic.org/transform/7b08bca0-382c-4978-b5e7-c8e99b58b898/21-CCC-2144209asymptomatic-COVID-table1_jpg)
The causes of thrombocytopenia can be divided into disorders of decreased platelet production and disorders of increased platelet consumption or destruction.
Disorders of decreased production include bone marrow diseases, such as myelodysplastic syndromes and aplastic anemia, and liver disease.
Disorders of platelet destruction or consumption include immune thrombocytopenic purpura and hemolytic processes. Thrombocytopenia can also occur during massive fluid resuscitation or blood transfusion without the transfusion of platelets, known as posttransfusion purpura, or during hypersplenism.1
Advertisement
Thrombotic thrombocytopenic purpura is caused by a genetic or acquired deficiency of ADAMTS13 (a disintegrin and metalloproteinase with a thrombospondin type 1 motif, member 13).
ADAMTS13 is a protease responsible for cleaving von Willebrand factor during times of high shear stress and resultant platelet adhesion, preventing large von Willebrand factor multimers from accumulating. A deficiency of ADAMTS13 leads to the accumulation of large von Willebrand factor multimers that platelets then attach to, leading to widespread microvascular thrombosis.1,2
The clinical features seen with thrombotic thrombocytopenic purpura are widespread and may include symptoms of thrombocytopenia and hemolytic anemia; renal dysfunction; neurologic impairment, including headaches, confusion, or even stroke and seizures; gastrointestinal symptoms such as nausea, vomiting, diarrhea, and abdominal pain; and fever. Laboratory findings include those typically seen in hemolytic anemia, including low haptoglobin, increased lactate dehydrogenase, and an increased reticulocyte count, as well as thrombocytopenia, schistocytes on peripheral blood smear, and possibly increased creatinine with proteinuria, hematuria, or both.2
The PLASMIC score3 can be used to predict the likelihood of ADAMTS13 deficiency in patients with thrombocytopenia and schistocytes. It is calculated by awarding 1 point for each of the following features, if present:
Advertisement
Disseminated intravascular coagulation is a clinical syndrome in which the processes of both coagulation and fibrinolysis are inappropriately activated, leading to bleeding, clotting, or both. The coagulation and fibrinolytic processes may be inappropriately activated during sepsis or in other conditions such as pregnancy or malignancy. Typical laboratory findings include prolonged prothrombin time and partial thromboplastin time, low levels of fibrinogen, increased levels of D-dimer, and findings consistent with microangiopathic hemolytic anemias.5
Immune thrombocytopenic purpura is an acquired, isolated thrombocytopenia modulated by platelet autoantibodies, with a platelet count less than 100 × 109/L.7 It is a diagnosis of exclusion, with clinical features of thrombocytopenia ranging from petechiae, mucosal bleeding, and easy bruising to internal bleeding and hemorrhagic stroke. Other than a low platelet count, laboratory data are typically normal.
Primary immune thrombocytopenic purpura is due to production of autoantibodies against platelets, whereas the secondary form can be triggered by many different conditions, including viral illnesses and autoimmune diseases.7,8
Glucose-6 phosphate dehydrogenase deficiency is an X-linked genetic disorder that can lead to hemolytic anemia after ingestion of certain foods or drugs. Glucose-6 phosphate dehydrogenase is an enzyme that protects red blood cells from oxidative injury, and lack of it renders red blood cells susceptible to oxidative damage. As a result, red blood cells are lysed during times of oxidative stress.9
Advertisement
Laboratory data reveal a hemolytic process, with schistocytes and bite cells on peripheral blood smear, decreased levels of haptoglobin, and increased lactate dehydrogenase. However, platelet counts and coagulation studies are typically unaffected.10 Therefore, this is the correct answer to the question above.
Hemolytic uremic syndrome is a thrombotic microangiopathy that is caused by infection with Shiga toxin-producing Escherichia coli and leads to acute kidney injury, hemolytic anemia, and thrombocytopenia. Clinical features typically include abdominal pain and a diarrheal illness, and laboratory data reveals a hemolytic process with increased lactate dehydrogenase and decreased levels of haptoglobin, schistocytes on peripheral blood smear, thrombocytopenia, normal ADAMTS13 levels, normal prothrombin time and partial thromboplastin time, and possibly rising creatinine, hematuria, proteinuria, and hypertension.11
The laboratory findings commonly seen in thrombotic thrombocytopenic purpura, hemolytic uremic syndrome, disseminated intravascular coagulation, and immune thrombocytopenic purpura are summarized in Table 2.

Image content: This image is available to view online.
View image online (https://assets.clevelandclinic.org/transform/e910eb67-337d-4234-ac56-af6c573eb11d/21-CCC-2144209asymptomatic-COVID-table2_jpg)
The patient’s complete blood cell count (Table 1), chemistry panel (Table 3), and other tests (Table 4) excluded other differential diagnostic considerations, including thrombotic thrombocytopenic purpura, disseminated intravascular coagulation, and other hemolytic processes. She had not received any transfusions (which would have suggested posttransfusion purpura), and she had not received any medications commonly associated with drug-induced thrombocytopenic purpura, such as beta-lactam antibiotics. A peripheral blood smear revealed thrombocytopenia and normal-appearing white and red blood cells, indicative of immune thrombocytopenic purpura (Figure 1).
Advertisement

Image content: This image is available to view online.
View image online (https://assets.clevelandclinic.org/transform/ea37a91c-daf4-4da4-a867-1c6d4b41cbdf/21-CCC-2144209asymptomatic-COVID-table3_jpg)

Image content: This image is available to view online.
View image online (https://assets.clevelandclinic.org/transform/b8cdfd2f-23a7-4b91-92a1-fc3f8548565a/21-CCC-2144209asymptomatic-COVID-table4_jpg)

Image content: This image is available to view online.
View image online (https://assets.clevelandclinic.org/transform/d42c3be1-3ef3-4276-bb36-7ddb15a9a105/21-CCC-2144209-SevereAsymptomatic-COVID-CCJM-CQD_650x450_jpg)
Figure 1. On the patient’s peripheral blood smear, no platelets were visible.
2. All of the following are causes of secondary immune thrombocytopenic purpura except which one?
Viral infections are often implicated in secondary immune thrombocytopenia, including hepatitis C, human immunodeficiency virus, many herpesviridae such as Epstein-Barr virus and cytomegalovirus, and others.12,13 Autoimmune disorders such as systemic lupus erythematosus, rheumatoid arthritis, and hematologic malignancies can be implicated in immune thrombocytopenic purpura as well. Chronic obstructive pulmonary disease, on the other hand, has not been documented as a cause of secondary immune thrombocytopenic purpura, although it can cause reactive polycythemia as a result of chronic hypoxia.14 Therefore, chronic obstructive pulmonary disease is the correct answer.
A nasal swab for SARS-CoV-2 — the cause of coronavirus disease 2019 (COVID-19) — was ordered, as is currently standard practice for all of our admitted patients, and her test was positive by polymerase chain reaction assay. The patient said she had no shortness of breath, cough, fevers or chills, diarrhea, anosmia, or dysgeusia on admission or in the past weeks or months. She did not need supplemental oxygen or intensive care. She said she had been compliant with mask-wearing and social distancing, but she worked for a cleaning company and had been in contact with many people and potentially contaminated surfaces.
In view of the pertinent negative findings described above and the temporal relationship between her symptoms and her positive SARS-CoV-2 test, we concluded that her otherwise-asymptomatic COVID-19 was the trigger for her severe thrombocytopenia.
3. All of the following are treatment options for severe secondary immune thrombocytopenic purpura except which one?
First-line treatment for severe secondary immune thrombocytopenia includes glucocorticoids, intravenous immunoglobulin, or both. Both are thought to interfere with the destruction of platelets.15 An additional first-line treatment is anti-D immunoglobulin. Second-line treatments include thrombopoietin receptor agonists, splenectomy, and rituximab.16
Plasma exchange is considered a first-line treatment for thrombotic thrombocytopenic purpura and serves to replace the deficient ADAMTS13 molecule. However, it is not typically used to treat immune thrombocytopenic purpura,16 and therefore this is the correct answer.
In the emergency department, the patient received 1 dose of dexamethasone 40 mg and 2 units of platelets. She was admitted to the hospital for two days, during which she received 2 doses of oral prednisone 1 mg/kg/day. She was discharged home on the third day with instructions to take an additional 2 doses of prednisone 1 mg/kg/day. A repeat complete blood count after she finished her course of steroids, five days after her initial presentation, revealed a platelet count of 268 × 109/L.
The thrombotic complications of COVID-19 have been well-documented.17–20 Thrombocytopenia can occur with COVID-19 by various mechanisms, including disseminated intravascular coagulation and sepsis.21
In addition, there have been multiple case reports of COVID-19–induced severe secondary thrombocytopenia (Table 5).22–28 The patients all had typical symptoms of COVID-19 such as cough, fever, or shortness of breath. The timing of thrombocytopenia varied, with some patients developing it early in their hospital course and others developing it days after admission. All patients, excluding one who died shortly after developing thrombocytopenia, were treated with intravenous immunoglobulin, corticosteroids, or both, with hematologic recovery in all reported cases. To our knowledge, however, ours is the first documented case of a SARS-CoV-2–positive patient presenting with symptomatic severe thrombocytopenia but no COVID-19 symptoms.

Image content: This image is available to view online.
View image online (https://assets.clevelandclinic.org/transform/b3b94c0f-7156-427e-b701-0764121e8221/21-CCC-2144209asymptomatic-COVID-table5-scaled_jpg)
This patient’s experience further reveals that SARS-CoV-2 can cause severe secondary immune thrombocytopenia, and is unique in showing that thrombocytopenia can be the sole presenting disorder in COVID-19. Hematologic monitoring of COVID-19 patients is becoming increasingly important, especially with respect to hypercoagulable complications,29 but attention must also be directed to platelet counts. Conversely, patients presenting with isolated thrombocytopenia should be screened for SARS-CoV-2 infection.
Editor’s note: This article originally appeared in the Cleveland Clinic Journal of Medicine.
References
1. Smock KJ, Perkins SL. Thrombocytopenia: an update. Int J Lab Hematol 2014; 36(3):269–278. doi:10.1111/ijlh.12214
2. Zander CB, Cao W, Zheng XL. ADAMTS13 and von Willebrand factor interactions. Curr Opin Hematol 2015; 22(5):452–459. doi:10.1097/MOH.0000000000000169CrossRefPubMedGoogle Scholar
3. Bendapudi PK, Hurwitz S, Fry A, et al. Derivation and external validation of the PLASMIC score for rapid assessment of adults with thrombotic microangiopathies: a cohort study. Lancet Haematol 2017; 4:e157–164. doi:10.1016/S2352-3026(17)30026-1CrossRefGoogle Scholar
4. Paydary K, Banwell E, Tong J, Chen Y, Cuker A. Diagnostic accuracy of the PLASMIC score in patients with suspected thrombotic thrombocytopenic purpura: a systematic review and meta-analysis. Transfusion 2020; 60(9):2047–2057. doi:10.1111/trf.15954CrossRefGoogle Scholar
5. Page EE, Kremer Hovinga JA, Terrell DR, Vesely SK, George JN. Thrombotic thrombocytopenic purpura: diagnostic criteria, clinical features, and long-term outcomes from 1995 through 2015. Blood Adv 2017; 1(10):590–600. doi:10.1182/bloodadvances.2017005124Abstract/FREE Full TextGoogle Scholar
6. Toh CH, Alhamdi Y, Abrams ST. Current pathological and laboratory considerations in the diagnosis of disseminated intravascular coagulation. Ann Lab Med 2016; 36(6):505–512. doi:10.3343/alm.2016.36.6.505CrossRefGoogle Scholar
7. Taylor FB Jr., Toh CH, Hoots WK, Wada H, Levi M. Towards definition, clinical and laboratory criteria, and a scoring system for disseminated intravascular coagulation. Thromb Haemost 2001; 86(5):1327–1330. pmid:11816725PubMedGoogle Scholar
8. Rodeghiero F, Stasi R, Gernsheimer T. Standardization of terminology, definitions and outcome criteria in immune thrombocytopenic purpura of adults and children: report from an international working group. Blood 2009; 113(11):2386–2393. doi:10.1182/blood-2008-07-162503Abstract/FREE Full TextGoogle Scholar
9. Liebman HA. Viral-associated immune thrombocytopenic purpura. Hematology Am Soc Hematol Educ Program 2008;212–218. doi:10.1182/asheducation-2008.1.212CrossRefGoogle Scholar
10. Beutler E. G6PD: population genetics and clinical manifestations. Blood Rev 1996; 10(1):45–52. doi:10.1016/s0268-960x(96)90019-3CrossRefPubMedGoogle Scholar
11. Edwards CQ. Anemia and the liver. Hepatobiliary manifestations of anemia. Clin Liver Dis 2002; 6(4):891–907. doi:10.1016/s1089-3261(02)00050-8CrossRefPubMedGoogle Scholar
12. Ruggenenti P, Noris M, Remuzzi G. Thrombotic microangiopathy, hemolytic uremic syndrome, and thrombotic thrombocytopenic purpura. Kidney Int 2001; 60(3):831–846. doi:10.1046/j.1523-1755.2001.060003831.xCrossRefPubMedGoogle Scholar
13. Cines DB, Bussel JB, Liebman HA, Luning Prak ET. The ITP syndrome: pathogenic and clinical diversity. Blood 2009; 113(26):6511–6521. doi:10.1182/blood-2009-01-129155Abstract/FREE Full TextGoogle Scholar
14. Chambellan A, Chailleux E, Similowski T, ANTADIR Observatory Group. Prognostic value of the hematocrit in patients with severe COPD receiving long-term oxygen therapy. Chest 2005; 128(3):1201–1208. doi:10.1378/chest.128.3.1201CrossRefPubMedGoogle Scholar
15. Mizutani H, Furubayashi T, Imai Y, et al. Mechanisms of corticosteroid action in immune thrombocytopenic purpura (ITP): experimental studies using ITP-prone mice, (NZW x BXSB) F1. Blood 1992; 79(4):942–947. pmid:1737103Abstract/FREE Full TextGoogle Scholar
16. Stasi R, Provan D. Management of immune thrombocytopenic purpura in adults. Mayo Clin Proc 2004; 79(4):504–522. doi:10.4065/79.4.504CrossRefPubMedGoogle Scholar
17. Klok FA, Kruip MJHA, van der Meer NJM, et al. Incidence of thrombotic complications in critically ill ICU patients with COVID-19. Thromb Res 2020; 191:145–147. doi:10.1016/j.thromres.2020.04.013CrossRefPubMedGoogle Scholar
18. Connors JM, Levy JH. COVID-19 and its implications for thrombosis and anticoagulation. Blood 2020; 135(23):2033–2040. doi:10.1182/blood.2020006000CrossRefPubMedGoogle Scholar
19. Ackermann M, Verleden SE, Kuehnel M, et al. Pulmonary vascular endothelialitis, thrombosis, and angiogenesis in covid-19. N Engl J Med 2020; 383(2):120–128. doi:10.1056/NEJMoa2015432CrossRefPubMedGoogle Scholar
20. Terpos E, Ntanasis-Stathopoulos I, Elalamy I, et al. Hematological findings and complications of COVID-19. Am J Hematol 2020; 95(7):834–847. doi:10.1002/ajh.25829CrossRefPubMedGoogle Scholar
21. Leisman DE, Deutschman CS, Legrand M. Facing COVID-19 in the ICU: vascular dysfunction, thrombosis, and dysregulated inflammation. Intensive Care Med 2020; 46(6):1105–1108. doi:10.1007/s00134-020-06059-6CrossRefPubMedGoogle Scholar
22. Hindilerden F, Yonal-Hindilerden I, Sevtap S, Kart-Yasar K. Immune thrombocytopenia in a very elderly patient with covid-19. Front Med (Lausanne) 2020; 7:404. doi:10.3389/fmed.2020.00404CrossRefGoogle Scholar
23. Tsao HS, Chason HM, Fearon DM. Immune thrombocytopenia (ITP) in a pediatric patient positive for SARS-CoV-2. Pediatrics 2020; 146(2):e20201419. doi:10.1542/peds.2020-1419Abstract/FREE Full TextGoogle Scholar
24. Artru F, Alberio L, Moradpour D, Stalder G. Acute immune thrombocytopaenic purpura in a patient with COVID-19 and decompensated cirrhosis. BMJ Case Rep 2020; 13(7):e236815. doi:10.1136/bcr-2020-236815CrossRefGoogle Scholar
25. Bennett J, Brown C, Rouse M, Hoffmann M, Ye Z. Immune thrombocytopenia purpura secondary to COVID-19. Cureus 2020; 12(7):e9083. doi:10.7759/cureus.9083CrossRefGoogle Scholar
26. Lévesque V, Millaire É, Corsilli D, Rioux-Massé B, Carrier F-M. Severe immune thrombocytopenic purpura in critical COVID-19. Int J Hematol 2020; 112(5):746–750. doi:10.1007/s12185-020-02931-9CrossRefGoogle Scholar
27. Murt A, Eskazan AE, Yılmaz U, Ozkan T, Ar MC. COVID-19 presenting with immune thrombocytopenia: a case report and review of the literature. J Med Virol 2020 Jun 4;10.1002/jmv.26138. doi:10.1002/jmv.26138CrossRefGoogle Scholar
28. Bomhof G, Mutsaers PGNJ, Leebeek FWG, et al. COVID-19-associated immune thrombocytopenia. Br J Haematol 2020; 190(2): e61–e64. doi:10.1111/bjh.16850CrossRefPubMedGoogle Scholar
29. Liu Y, Sun W, Guo Y, et al. Association between platelet parameters and mortality in coronavirus disease 2019: retrospective cohort study. Platelets 2020; 31(4):490–496. doi:10.1080/09537104.2020.1754383CrossRefGoogle Scholar
Advertisement
Patients report improved sense of smell and taste
Clinicians who are accustomed to uncertainty can do well by patients
Unique skin changes can occur after infection or vaccine
Cleveland Clinic analysis suggests that obtaining care for the virus might reveal a previously undiagnosed condition
As the pandemic evolves, rheumatologists must continue to be mindful of most vulnerable patients
Early results suggest positive outcomes from COVID-19 PrEP treatment
Could the virus have caused the condition or triggered previously undiagnosed disease?